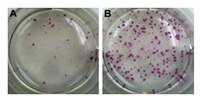

SCM087 Sigma-AldrichMouse iPS Reprogramming Boost Supplement
The Mouse iPS Reprogramming Boost Supplement enhances the efficiency of mouse iPS colony formation by at least 3-fold.
More>> The Mouse iPS Reprogramming Boost Supplement enhances the efficiency of mouse iPS colony formation by at least 3-fold. Less<<Recommended Products
Overview
| Replacement Information |
|---|
| References |
|---|
| Product Information | |
|---|---|
| Components |
|
| Quality Level | MQ100 |
| Applications | |
|---|---|
| Application | The Mouse iPS Reprogramming Boost Supplement enhances the efficiency of mouse iPS colony formation by at least 3-fold. |
| Biological Information | |
|---|---|
| Media Form | Liquid |
| Stem Cell Type |
|
| Physicochemical Information |
|---|
| Dimensions |
|---|
| Materials Information |
|---|
| Toxicological Information |
|---|
| Safety Information according to GHS |
|---|
| Safety Information |
|---|
| Packaging Information | |
|---|---|
| Material Size | 1 kit |
| Transport Information |
|---|
| Supplemental Information |
|---|
| Specifications |
|---|
| Global Trade Item Number | |
|---|---|
| Catalogue Number | GTIN |
| SCM087 | 04053252557460 |
Documentation
Mouse iPS Reprogramming Boost Supplement SDS
| Title |
|---|
Brochure
| Title |
|---|
| Stem Cell Research |
User Guides
| Title |
|---|
| Mouse iPS Cell Boost Supplement |